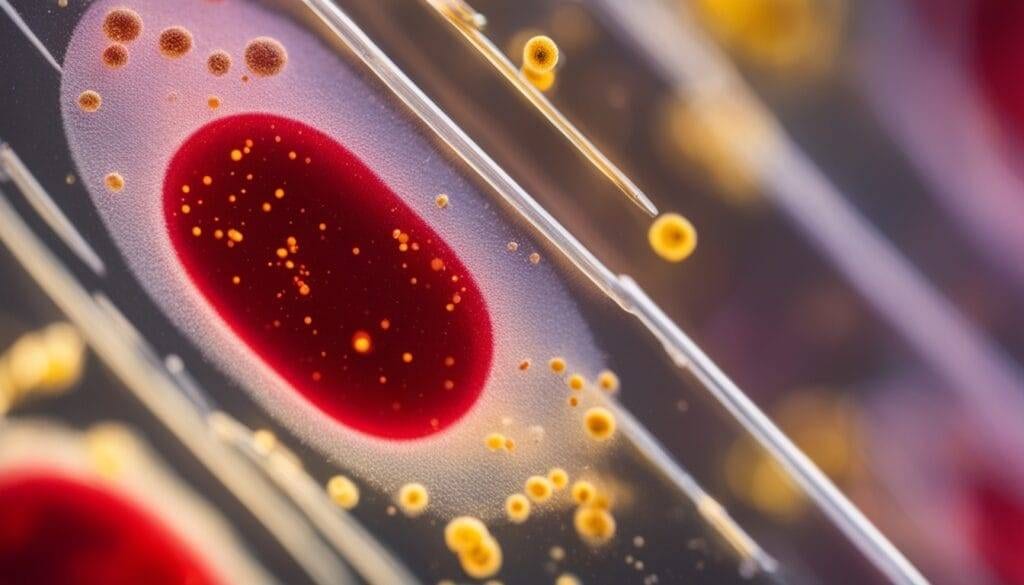
penyakit yang dapat dideteksi

Syarat Cek Kesehatan Pra Nikah di Puskesmas – Apakah Anda tahu bahwa pemeriksaan kesehatan pra nikah bisa menyelamatkan nyawa? Di Indonesia, tantangan kesehatan menghampiri pasangan yang akan menikah. Ini termasuk tingkat kematian ibu dan bayi yang tinggi serta kasus stunting.
Di puskesmas, kita bisa memastikan calon pengantin sehat dan siap nikah. Cek ini penting untuk mendapatkan sertifikat layak nikah. Sertifikat ini wajib ada sebelum menikah.
Apa syarat cek kesehatan pra nikah di puskesmas ? Mari kita pelajari lebih lanjut. Ini penting agar kita siap dan tak terlewat sebelum hari bahagia.
Poin Kunci
- Pemeriksaan kesehatan pra nikah membantu mencegah masalah kesehatan bagi ibu dan bayi.
- Sertifikat Layak Nikah adalah dokumen wajib sebelum menikah.
- Cek kesehatan sebaiknya dilakukan 90 hari sebelum pernikahan.
- Dokumen seperti KTP dan surat rekomendasi diperlukan untuk pendaftaran.
- Biaya cek kesehatan di puskesmas mulai dari Rp27.000.
Pengertian Cek Kesehatan Pra Nikah
Cek kesehatan pra nikah adalah serangkaian pemeriksaan untuk memastikan kesehatan fisik dan mental calon pengantin, termasuk berkonsultasi dengan psikolog pernikahan Jakarta untuk kesiapan emosional. Ini penting agar pasangan bisa mengambil langkah-langkah preventif. Mereka harus tahu pengertian cek kesehatan pra nikah.
Pemeriksaan ini termasuk evaluasi kesehatan umum, laboratorium, dan uji reproduksi. Tujuannya adalah mendeteksi penyakit menular. Penyakit ini bisa merusak kualitas hidup pernikahan dan kesehatan anak.
Ini sangat penting untuk calon pengantin, terutama jika ada riwayat kesehatan keluarga. Dengan proses ini, pasangan bisa tahu kesehatan mereka. Mereka bisa merencanakan langkah-langkah menuju kehidupan pernikahan yang sehat.

Baca Juga: Persiapan Mental Sebelum Menikah Menurut Islam adalah Kunci Kebahagiaan Rumah Tangga
Manfaat Cek Kesehatan Pra Nikah
Memeriksa kesehatan sebelum menikah itu penting banget. Ini bisa deteksi gangguan kesehatan yang tak terlihat, seperti thalasemia atau infeksi seksual. Dengan pemeriksaan, kita bisa cegah masalah kesehatan dan pastikan pernikahan sehat.
Ini juga bantu pasangan rencanakan kehamilan dengan lebih baik. Cegah cacat bawaan janin dengan deteksi infeksi TORCH. Tes HIV, hepatitis B, dan C penting, khususnya untuk melindungi bayi.

Pemeriksaan kadar gula darah bisa tahu risiko diabetes. Analisis sperma untuk pria dan USG kandungan untuk wanita penting.
Memenuhi kebutuhan vitamin dan mineral, seperti asam folat, siapkan tubuh buat kehidupan baru. Cek kesehatan sebelum nikah itu sangat bermanfaat buat masa depan kita.
Syarat Cek Kesehatan Pra Nikah di Puskesmas
Untuk cek kesehatan pra nikah di puskesmas, ada syarat yang harus dipenuhi. Penting untuk memahami ini agar pendaftaran berjalan lancar. Kita perlu mengetahui dokumen yang dibutuhkan dan prosedur pendaftaran.
Dokumen yang Harus Dibawa
Kita harus membawa dokumen penting untuk verifikasi identitas. Dokumen-dokumen ini meliputi:
- Fotocopy KTP calon pengantin
- Kartu JKN/BPJS Kesehatan
- Surat pengantar dari RT/RW
- Dokumen identitas pasangan
Prosedur Pendaftaran di Puskesmas
Setelah dokumen syarat cek kesehatan pra nikah di puskesmas siap, kita harus mengikuti prosedur pendaftaran. Mulailah dengan mengambil nomor antrian di bagian pendaftaran. Petugas akan konfirmasi identitas dan lakukan anamnesis. Proses ini memakan waktu sekitar 20 menit.

Tes Kesehatan Sebelum Menikah di Puskesmas
Kesehatan penting banget sebelum menikah. Ada tes kesehatan pra nikah puskesmas. Tes ini meliputi pemeriksaan darah dan pemeriksaan gizi.
Pemeriksaan Darah
Pemeriksaan darah penting dalam tes kesehatan pra nikah. Ini bisa deteksi kondisi kesehatan yang tak terlihat. Beberapa parameter yang dicek termasuk:
- Uji golongan darah dan rhesus untuk mengetahui kompatibilitas darah pasangan.
- Hitung darah lengkap untuk cek anemia atau infeksi, melalui Hb, sel darah putih, dan trombosit.
- Screening TORCH untuk cek infeksi yang berpengaruh pada kehamilan, seperti toksoplasmosis dan rubella.
- Uji HIV dan Hepatitis B untuk mencegah penyebaran penyakit ke anak.
Pemeriksaan Gizi
Pemeriksaan gizi penting dalam tes kesehatan pra nikah. Ini untuk mengevaluasi kebugaran fisik calon pengantin. Beberapa aspek penting dalam pemeriksaan gizi adalah:
- Penilaian status gizi dengan pengukuran lingkar lengan.
- Saran diet khusus untuk wanita, termasuk suplementasi asam folat sebelum hamil untuk mencegah cacat lahir, serta informasi tentang makanan puasa mutih pengantin untuk mempersiapkan diri secara tradisional. Cek kadar gula darah untuk risiko diabetes dan pencegahan diabetes gestasional.

Baca Juga: Pengajian Sebelum Pernikahan dalam Islam: Menggapai Ridha Allah?
Jenis Penyakit yang Dapat Dideteksi
Pemeriksaan kesehatan sebelum menikah sangat penting. Ini membantu kita mengetahui kondisi kesehatan kita dan pasangan. Dengan pemeriksaan ini, kita bisa mengambil langkah-langkah untuk masa depan yang lebih sehat.
Ada beberapa penyakit yang bisa dideteksi lewat tes kesehatan ini. Mari kita lihat beberapa contohnya.
Penyakit Genetik Seperti Thalasemia
Thalasemia adalah penyakit genetik yang bisa diturunkan. Ini bisa menyebabkan masalah dengan produksi hemoglobin. Oleh karena itu, tes genetik untuk thalasemia sangat penting, terutama jika ada riwayat keluarga dengan penyakit ini.
Dengan tes sebelum menikah, kita bisa merencanakan cara pencegahan. Ini penting untuk kesehatan anak kita di masa depan.
Infeksi Menular Seksual
Infeksi menular seksual juga penting untuk diperiksa. Penyakit seperti HIV, hepatitis B, dan gonore bisa tidak menunjukkan gejala. Oleh karena itu, tes ini sangat penting untuk kesehatan reproduksi kita.
Ini juga membantu menghindari komplikasi di masa depan. Kita bisa menjaga kesehatan kita dan pasangan dengan baik.
| Jenis Penyakit | Deteksi | Pencegahan |
|---|---|---|
| Thalasemia | Tes genetik | Kesadaran keluarga, skrining awal |
| Infeksi Menular Seksual | Tes darah dan urin | Penggunaan proteksi, rutin check-up |
Dengan pemeriksaan kesehatan sebelum menikah, kita bisa menikah dengan lebih siap. Kita bisa mengurangi risiko penyakit dan menjaga kesehatan reproduksi kita dan anak-anak kita.
Biaya Cek Kesehatan Pra Nikah di Puskesmas
Memilih biaya cek kesehatan pra nikah di puskesmas adalah langkah penting. Biaya tes kesehatan catin di puskesmas berkisar dari Rp 20.000 hingga Rp 50.000. Ini jauh lebih murah dibandingkan biaya di rumah sakit yang bisa mencapai Rp 1.000.000 hingga Rp 3.000.000.
Di puskesmas, kita bisa melakukan berbagai tes kesehatan seperti pemeriksaan darah dan tes penyakit menular. Bagi yang berlangganan BPJS Kesehatan, layanan ini gratis. Untuk yang tidak berlangganan, biaya cek kesehatan nikah di puskesmas tidak lebih dari Rp 100.000.

Biaya cek kesehatan di puskesmas tidak hanya murah tapi juga memberikan akses ke berbagai tes kesehatan. Ini termasuk tes darah, penyakit menular, dan vaksinasi. Berikut adalah beberapa biaya cek kesehatan untuk menikah yang umum:
| Jenis Tes | Biaya (Rp) |
|---|---|
| Paket Medical Check Up Pranikah | 328.000 |
| Paket lengkap (dengan pemeriksaan TORCH) | 2.019.000 |
| Pemeriksaan Sperma Pria | 414.000 |
| Pemeriksaan Jantung | 946.000 |
| Foto Thorax | 96.000 |
Dengan informasi ini, kita bisa memilih cek kesehatan pra nikah yang tepat. Layanan di puskesmas yang terjangkau adalah langkah awal yang baik untuk persiapan pernikahan.
Waktu dan Tempat untuk Cek Kesehatan
Waktu terbaik untuk cek kesehatan sebelum menikah adalah tiga bulan sebelum hari pernikahan. Ini memberi calon pengantin waktu untuk memeriksa kesehatan dan mengatasi masalah jika ada. Puskesmas terdekat adalah tempat yang baik untuk melakukan pemeriksaan ini. Sebelumnya, kita harus mendaftar untuk mendapatkan layanan yang optimal.
Cek kesehatan ini penting untuk memastikan pasangan sehat dan siap untuk bersama. Berikut informasi tentang waktu dan tempat cek kesehatan:
| Aspek | Keterangan |
|---|---|
| Waktu Ideal Cek Kesehatan | 6 bulan sebelum pernikahan |
| Waktu Minimal Cek Kesehatan | 3 bulan sebelum pernikahan |
| Tempat Cek Kesehatan | Puskesmas terdekat sesuai dengan domisili |
| Biaya Cek Kesehatan | Dibiayai oleh pemerintah |
Kita bisa menghubungi puskesmas terdekat untuk info lebih lanjut tentang cek kesehatan. Cek kesehatan sebelum menikah itu penting. Ini bisa mengurangi risiko masalah kesehatan di masa depan.

Baca Juga: Memahami Psikologi Rumah Tangga Harmonis: Panduan Lengkap untuk Keluarga Bahagia
Proses Mendapatkan Sertifikat Layak Nikah
Untuk mendapatkan sertifikat layak nikah, calon pengantin harus melewati beberapa tahapan penting. Salah satu tahapannya adalah pemeriksaan kesehatan yang harus dilakukan paling lambat satu bulan sebelum pernikahan. Biaya cek kesehatan ini sekitar Rp90 ribu, terutama untuk warga non-DKI Jakarta yang tidak terdaftar di BPJS Kesehatan.
Setelah cek kesehatan, calon pengantin akan mendapatkan surat keterangan sehat. Surat ini penting sebagai syarat untuk mendaftar di KUA.
Contoh Surat KETERANGAN Sehat untuk Menikah
Setelah cek kesehatan, bakal pasangan suami istri akan menerima surat keterangan sehat. Surat ini berisi identitas, hasil pemeriksaan, dan status kesehatan. Formatnya umumnya seperti ini:
| Rincian | Keterangan |
|---|---|
| Nama Calon Pengantin | [Nama Lengkap] |
| Nomor KTP | [Nomor KTP] |
| Hasil Pemeriksaan Kesehatan | [Deskripsi Hasil] |
| Tanggal Pemeriksaan | [Tanggal Pemeriksaan] |
| Tanda Tangan Dokter | [Nama dan Tanda Tangan] |

Surat sehat untuk nikah apakah harus dari puskesmas? Tidak wajib, selama surat tersebut: Menyatakan hasil pemeriksaan kesehatan calon pengantin, dikeluarkan oleh fasilitas kesehatan resmi (puskesmas, klinik, rumah sakit), dan ditandatangani oleh dokter yang memiliki SIP (Surat Izin Praktik).
Untuk Sertifikat Layak Kawin, calon pengantin perlu dokumen seperti fotokopi KTP dan surat rekomendasi RT/RW. Kami harapkan proses ini berjalan lancar dan cepat bagi semua calon pengantin.
Tips untuk Calon Pengantin sebelum Pemeriksaan
Sebelum pemeriksaan kesehatan pranikah, ada beberapa tips calon pengantin yang penting. Pastikan kita tidur cukup malam sebelumnya. Tidur yang baik membantu tubuh kita sehat dan stabil.
Memilih makanan sehat juga penting dalam persiapan pemeriksaan kesehatan. Makanan bergizi sebelum pemeriksaan mendukung kesehatan kita. Jangan konsumsi alkohol dan obat-obatan bukan resep untuk hasil akurat.
Siapkan dokumen yang dibutuhkan untuk pemeriksaan. Bawa kartu identitas, kartu keluarga, dan kartu asuransi kesehatan. Ini penting dalam persiapan nikah.

Dengan mengikuti tips ini, pemeriksaan kesehatan pranikah akan lancar. Kita jadi lebih tenang dan siap untuk hari bahagia.
Daftar Online Cek Kesehatan Pra Nikah di Puskesmas
Banyak puskesmas sekarang menawarkan daftar online cek kesehatan untuk membantu calon pengantin. Mendaftar secara online memungkinkan calon pengantin memperkirakan nomor antrean dan menghemat waktu. Ini membantu menghindari antrean panjang di layanan kesehatan.
Pendaftaran dilakukan melalui situs resmi atau aplikasi puskesmas. Di Puskesmas Kecamatan Grogol Petamburan, hanya satu individu yang bisa mendaftar. Layanan ini tersedia dari 7:30 hingga 11:00. Ada beberapa dokumen yang harus dibawa, seperti:
- Fotocopy KTP calon pengantin.
- Fotocopy KTP pasangan.
- Surat rekomendasi dari ketua RT/RW setempat.
Pemeriksaan kesehatan ini gratis untuk warga DKI Jakarta. Namun, biaya berbeda untuk non-warga DKI Jakarta, sesuai Peraturan Daerah No. 143 tahun 2018. Penting untuk memahami masa maksimum pemeriksaan adalah tiga bulan sebelum hari pernikahan.
Kami sarankan calon pengantin untuk memeriksa syarat dan prosedur di puskesmas. Hubungi hotlines atau WhatsApp untuk informasi lebih lanjut.

| Dokumen Wajib | Keterangan |
|---|---|
| Fotocopy KTP Calon Pengantin | Identifikasi pribadi calon pengantin |
| Fotocopy KTP Pasangan | Identifikasi pribadi pasangan |
| Surat Rekomendasi RT/RW | Diperlukan untuk pendaftaran pernikahan |
Tes Kesehatan Sebelum Menikah Tapi Sudah Hamil
Bagi kita yang sudah hamil namun masih dalam proses menuju pernikahan, melakukan cek kesehatan adalah hal yang esensial. Mekanisme ini tidak hanya berfokus pada kesehatan fisik calon pengantin tetapi juga memprioritaskan kesehatan ibu hamil dan janin. Berbagai tes kesehatan hamil harus dipersiapkan, yang mencakup pemeriksaan darah, golongan darah dan faktor Rh, serta tes urine.
Pemeriksaan ini bertujuan untuk mendeteksi kemungkinan risiko seperti anemia atau komplikasi selama kehamilan. Misalnya, pemeriksaan darah dapat membantu kita mengetahui kadar hemoglobin dan jaringan darah lainnya. Cek golongan darah penting untuk memastikan kecocokan saat transfusi jika diperlukan. Selain itu, pemeriksaan kadar gula darah dan tes penyakit menular seksual juga menjadi bagian penting dalam memastikan kesehatan ibu hamil serta menghindari risiko yang mungkin memengaruhi calon buah hati.
Selama proses ini, kita sebaiknya menjaga kesehatan tubuh, seperti dengan beristirahat yang cukup dan mempersiapkan diri sebelum melakukan pemeriksaan calon pengantin. Jika kita memiliki kondisi kesehatan tertentu, penting untuk membawa hasil tes sebelumnya untuk membantu dokter memberikan diagnosis yang akurat. Mari kita pastikan kesehatan ibu hamil dan bayi tetap terjaga demi masa depan yang lebih baik.
FAQ Syarat Cek Kesehatan Pra Nikah di Puskesmas
Apa itu cek kesehatan pra nikah?
Cek kesehatan pra nikah adalah pemeriksaan untuk memastikan kedua calon pengantin sehat. Ini termasuk evaluasi kesehatan umum dan pemeriksaan penyakit menular.
Dokumen apa saja yang perlu saya bawa untuk cek kesehatan pra nikah?
Anda perlu membawa fotocopy KTP, kartu JKN/BPJS Kesehatan, surat pengantar dari RT/RW, dan dokumen identitas pasangan.
Di mana saya bisa melakukan cek kesehatan pra nikah?
Anda bisa melakukan cek kesehatan di puskesmas kecamatan terdekat.
Apakah biaya cek kesehatan pra nikah akan berbeda untuk peserta JKN/KIS dan non peserta?
Biaya cek kesehatan pra nikah berbeda. Peserta JKN/KIS tidak dikenakan biaya. Sementara yang bukan peserta harus membayar sesuai tarif.
Kapan sebaiknya saya melakukan cek kesehatan pra nikah?
Lakukan cek kesehatan paling lambat tiga bulan sebelum pernikahan.
Apa manfaat dari cek kesehatan pra nikah?
Manfaatnya termasuk deteksi dini gangguan kesehatan. Ini membantu perencanaan kehamilan dan mengurangi risiko komplikasi.
Apa saja jenis pemeriksaan yang dilakukan dalam cek kesehatan pra nikah?
Pemeriksaan meliputi tes darah, pemeriksaan gizi, dan deteksi penyakit menular serta genetik.
Bagaimana proses mendapatkan sertifikat layak nikah?
Setelah pemeriksaan selesai, calon pengantin akan dapat sertifikat layak nikah. Ini menandakan mereka sehat untuk menikah.
Apakah cek kesehatan pra nikah juga penting untuk calon pengantin yang sudah hamil?
Ya, penting untuk memastikan kesehatan ibu dan janin selama kehamilan dan melahirkan.
Apakah ada pendaftaran online untuk cek kesehatan pra nikah?
Banyak puskesmas menawarkan pendaftaran online. Ini memudahkan calon pengantin dalam mengambil nomor antrean.
Link Sumber
- https://www.idntimes.com/life/relationship/robertus-ari/biaya-cek-kesehatan-pra-nikah-di-puskesmas – Biaya Cek Kesehatan Pra Nikah di Puskesmas
- https://www.haibunda.com/kehamilan/20230504141745-49-303941/persiapan-dan-syarat-cek-kesehatan-ke-puskesmas-untuk-dapatkan-sertifikat-layak-nikah – Persiapan dan Syarat Cek Kesehatan ke Puskesmas untuk Dapatkan Sertifikat Layak Nikah
- https://semarangkota.go.id/p/965/pemeriksaan_kesehatan_pra_nikah_bagi_pasangan_calon_pengantin – Pemeriksaan Kesehatan Pra Nikah Bagi Pasangan Calon Pengantin
- https://yankes.kemkes.go.id/view_artikel/2184/cek-kesehatan-pra-nikah-untuk-kebaikan-bersama – Direktorat Jenderal Pelayanan Kesehatan
- https://www.halodoc.com/kesehatan/cek-pra-nikah – Apa Itu Cek Up Pranikah? Prosedur dan Informasi Lengkap | Halodoc
- https://www.klikdokter.com/info-sehat/review/tes-kesehatan-yang-harus-dilakukan-sebelum-menikah – 7 Tes Kesehatan yang Perlu Dilakukan Sebelum Kamu Menikah
- https://bumame.com/blog/tips-kesehatan/cek-kesehatan-sebelum-menikah/ – Cek Kesehatan Sebelum Menikah: Tujuan, Jenis, dan Waktu Tes – Bumame
- https://sippn.menpan.go.id/pelayanan-publik/8035643/dinas-kesehatan/standar-pelayanan-kesehatan-reproduksi-calon-pengantin – Sistem Informasi Pelayanan Publik
- https://catin-puskesmasgrogolpetamburan.jakarta.go.id/ – Pelayanan Calon Pengantin
- https://genbest.id/articles/5-tes-kesehatan-untuk-wanita-sebelum-menikah – 5 Tes Kesehatan untuk Wanita Sebelum Menikah
- https://kimiafarmaapotek.co.id/id/8-test-premarital-untuk-mendeteksi-penyakit-bagi-pasangan-suami-istri/ – 8 Test Premarital Untuk Mendeteksi Penyakit bagi Pasangan Suami & Istri – Kimia Farma Apotek
- https://skata.info/article/detail/1421/terlambat-cek-kesehatan-pranikah-apa-risikonya – Terlambat Cek Kesehatan Pranikah, Apa Risikonya?
- https://nakita.grid.id/read/024001517/biaya-cek-kesehatan-pranikah-di-puskesmas-dan-rumah-sakit-cek-di-sini?page=all – Biaya Cek Kesehatan Pranikah di Puskesmas dan Rumah Sakit, Cek di Sini! – Semua Halaman – Nakita
- https://www.halodoc.com/artikel/ini-kisaran-biaya-medical-check-up-standar-pemerintah-dan-manfaatnya – Ini Kisaran Biaya Medical Check Up Standar Pemerintah dan Manfaatnya
- https://skata.info/article/detail/385/pentingnya-cek-kesehatan-pranikah – Pentingnya Cek Kesehatan Pranikah
- https://www.kompas.com/tren/read/2022/03/15/083000465/kemenag-wajibkan-calon-pengantin-cek-kesehatan-sebelum-menikah-apa?page=all – Kemenag Wajibkan Calon Pengantin Cek Kesehatan Sebelum Menikah, Apa Alasannya? Halaman all – Kompas.com
- https://puskesmasbagansiapiapi.rohilkab.go.id/detailpost/pentingnya-pemeriksaan-kesehatan-pra-nikah – Post – Pentingnya Pemeriksaan Kesehatan Pra Nikah
- https://www.cermati.com/artikel/cara-buat-sertifikat-layak-kawin-wajib-buat-kamu-yang-mau-nikah-di-jakarta – Cara Buat Sertifikat Layak Kawin, Wajib Buat Kamu yang Mau Nikah di Jakarta – Cermati.com
- https://hellosehat.com/sehat/tes-kesehatan/pria-tes-kesehatan-sebelum-menikah/ – 5 Tes Kesehatan Sebelum Menikah yang Wajib Dilakukan Pria
- https://tirto.id/syarat-tes-kesehatan-catin-dan-cek-e-certificate-di-jaksehat-gzQ7 – Syarat Tes Kesehatan Catin dan Cek E-Certificate di JakSehat
- https://surabaya.kompas.com/read/2023/04/12/205751078/kelas-calon-pengantin-syarat-cara-daftar-dan-link-cek-sertifikat – Kelas Calon Pengantin: Syarat, Cara Daftar, dan Link Cek Sertifikat
- https://lifestyle.kompas.com/read/2022/10/27/121941520/7-tes-kesehatan-berikut-wajib-dilakukan-calon-pengantin-sebelum-menikah?page=all – 7 Tes Kesehatan Berikut Wajib Dilakukan Calon Pengantin Sebelum Menikah
- https://genbest.id/articles/persiapkan-ini-sebelum-tes-kesehatan-pranikah – Persiapkan ini Sebelum Tes Kesehatan Pranikah



